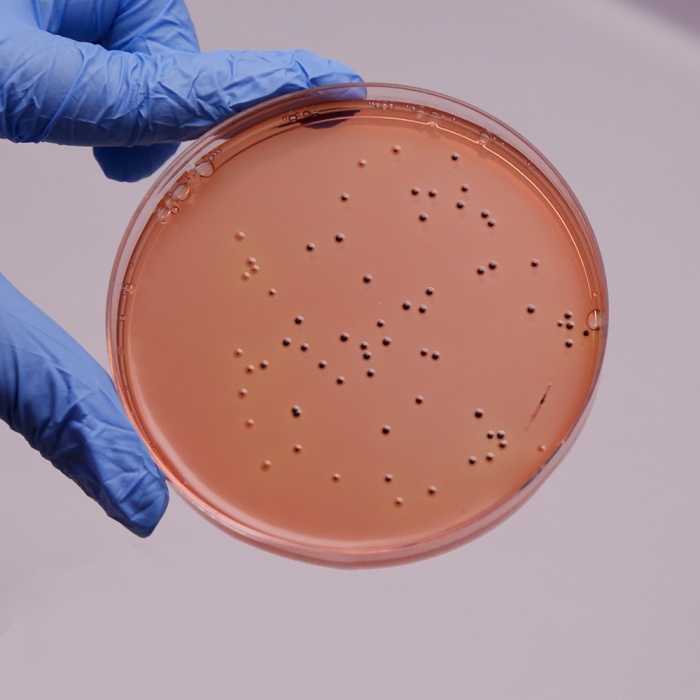

Your enquiry has been submitted
Sakazakii DHL Agar
Intended Use
Recommended for the detection and isolation of pathogenic Enterobacteriaceae from all types of specimens.
Composition**
| Ingredients | g / L |
|---|---|
| Tryptone | 10.000 |
| HM peptone # | 10.000 |
| HM extract $ | 3.000 |
| Lactose | 10.000 |
| Sucrose | 10.000 |
| L-Cysteine hydrochloride monohydrate | 0.200 |
| Sodium citrate | 1.000 |
| Sodium deoxycholate | 1.500 |
| Sodium thiosulphate | 2.000 |
| Ammonium iron (III) citrate | 1.000 |
| Neutral red | 0.030 |
| Agar | 15.000 |
Final pH ( at 25°C): 7.2±0.2
**Formula adjusted, standardized to suit performance parameters
# Equivalent to Meat peptone
$ Equivalent to Meat extract
Directions
Suspend 63.71 grams (the equivalent weight of dehydrated medium per litre) in 1000 ml purified/distilled water. Heat to boiling to dissolve the medium completely. Sterilize by autoclaving at 15 lbs pressure (121°C) for 15 minutes. Cool to 45-50°C. Mix well and pour into sterile Petri plates.
Principle And Interpretation
Enterobacteriaceae have wide distribution. Many members form the normal gut and intestinal microflora in humans and animals. They are also found on plants and in soils and water (1). Some species occupy very limited ecological niches. They are a major component of the normal intestinal flora of humans but are relatively uncommon at other body sites. They account for nearly 50% of septicemia cases, more than 70% of urinary tract infections and a significant percentage of intestinal infections (2).
Sakazakii DHL Agar is modified Deoxycholate Agar (M065) as described by Sakazakii et al (3,4). Sakazakii DHL Agar stands for Sakazakii Deoxycholate-Hydrogen sulphide-Lactose Agar. The medium is selective for the identification and isolation of Enterobacteriaceae due to inclusions of sodium deoxycholate. Sodium deoxycholate inhibits gram-positive bacteria and also prevents swarming growth of Proteus species. However due to the low concentration of sodium deoxycholate coupled with the nutritionally rich media, fastidious strains of Salmonella and Shigella are able to grow on this medium. Sulphur is released from thiosulphate or other sulphur-containing compounds in the form of sulphide. The H2S thus produced is detected by ferric ammonium citrate to form insoluble heavy metal sulphides that appear as a black precipitate (5). Proteus, Morganella, Rettgerella and Providencia colonies are surrounded by dark brown zones due to phenylalanine deamination. Phenylalanine is sourced from peptone that forms an iron complex with the ferric ions. The high concentration of sucrose in the medium permits the recovery of sucrose positive and lactose negative members of Enterobacteriaceae.
Type of specimen
Clinical- faeces; Food samples.
Specimen Collection and Handling
For clinical samples follow appropriate techniques for handling specimens as per established guidelines (7,8). For food samples, follow appropriate techniques for sample collection and processing as per guidelines (6). After use, contaminated materials must be sterilized by autoclaving before discarding.
Warning and Precautions
In Vitro diagnostic use. For professional use only. Read the label before opening the container. Wear protective gloves/protective clothing/eye protection/face protection. Follow good microbiological lab practices while handling specimens and culture. Standard precautions as per established guidelines should be followed while handling clinical specimens. Safety guidelines may be referred in individual safety data sheets.
Limitations
- Further biochemical identification is required for confirmation of species.
- Individual organisms differ in their growth requirement and may show variable growth patterns on the medium.
- Each lot of the medium has been tested for the organisms specified on the COA. It is recommended to users to validate the medium for any specific microorganism other than mentioned in the COA based on the user’s unique requirement.
Performance and Evaluation
Performance of the medium is expected when used as per the direction on the label within the expiry period when stored at recommended temperature.
Quality Control
Appearance: Light yellow to light pink homogeneous free flowing powder
Gelling: Firm, comparable with 1.5% Agar gel.
Colour and Clarity of prepared medium: Red coloured clear to slightly opalescent gel forms in Petri plates
Reaction: Reaction of 6.37% w/v aqueous solution at 25°C pH : 7.2±0.2
pH: 7.00-7.40
Cultural Response
Cultural characteristics observed after an incubation at 35-37°C for 24-48 hours.
| Organism | Inoculum (CFU) | Growth | Recovery | Colour of colony | H2S production |
|---|---|---|---|---|---|
| Escherichia coli ATCC 25922 (00013*) | 50-100 | good-luxuriant | >=50% | red with bile precipitate | negative |
| Klebsiella pneumoniae ATCC 10031 | 50-100 | good-luxuriant | >=50% | pink | negative |
| Salmonella Typhimurium ATCC 14028 (00031*) | 50-100 | good-luxuriant | >=50% | colourless | positive |
| Salmonella Enteritidis ATCC 13076 (00030*) | 50-100 | good-luxuriant | >=50% | colourless | positive |
| ## Proteus hauseri ATCC 13315 | 50-100 | fair-good | 30-40% | pink with brownish zone | negative |
| Proteus mirabilis ATCC 25933 | 50-100 | good-luxuriant | >=50% | colourless with brownish zone | variable |
| Shigella flexneri ATCC 12022 (00126*) | 50-100 | fair-good | 30-40% | colourless | negative |
| Staphylococcus aureus subsp. aureus ATCC 25923 (00034*) | >=104 | inhibited | 0% | - | - |
| Enterococcus faecalis ATCC 29212 (00087*) | 50-100 | none-poor | <=10% | colourless | negative |
| Bacillus cereus ATCC 10876 | >=104 | inhibited | 0% | - | - |
Key : *Corresponding WDCM numbers. ## Formerly known as Proteus vulgaris
Storage and Shelf Life
Store between 10-30°C in a tightly closed container and the prepared medium at 20-30°C. Use before expiry date on the label. On opening, product should be properly stored dry, after tightly capping the bottle in order to prevent lump formation due to the hygroscopic nature of the product. Improper storage of the product may lead to lump formation. Store in dry ventilated area protected from extremes of temperature and sources of ignition Seal the container tightly after use. Product performance is best if used within stated expiry period.
Disposal
User must ensure safe disposal by autoclaving and/or incineration of used or unusable preparations of this product. Follow established laboratory procedures in disposing of infectious materials and material that comes into contact with clinical sample must be decontaminated and disposed of in accordance with current laboratory techniques (7,8).
Reference
- Krieg N. R. and Holt J. G., (Eds.), 1984, Bergeys Manual of Systematic Bacteriology Vol. I, P-408-516. Williams and Wilkins Co. Baltimore.
- Murray P. R., Baron J. H., Pfaller M. A., Jorgensen J. H. and Yolken R. H., (Ed.), 2003, Manual of Clinical Microbiology, 8th Ed., American Society for Microbiology, Washington, D.C.
- Sakazakii R., Namioka S., Osada A., a. Yamada C. A., 1960, Japan. J. Ex. Med., 30; 13-22.
- Sakazakii R., Tamura K., Prescott L. M., Benzic Z., Sanyal S. C., a. Sinha, R., 1971, Indian J. Med. Res., 59; 1025-1034.
- Koneman E. W., Allen S. D., Janda W. M., Schreckenberger P. C., Winn W.C. Jr., 1992, Colour Atlas and Textbook of Diagnostic Microbiology, 4 th Ed., J. B. Lippinccott Company.
- Salfinger Y., and Tortorello M.L., 2015, Compendium of Methods for the Microbiological Examination of Foods, 5th Ed., American Public Health Association, Washington, D.C.
- Isenberg, H.D. Clinical Microbiology Procedures Handbook 2nd Edition.
- Jorgensen, J.H., Pfaller, M.A., Carroll, K.C., Funke, G., Landry, M.L., Richter, S.S and Warnock., D.W. (2015) Manual of Clinical Microbiology, 11th Edition. Vol. 1.
| Product Name | Sakazakii DHL Agar |
|---|---|
| SKU | M1619 |
| Product Type | Regular |
| Physical Form | Powder |
| Origin | Animal |
| Packaging type | HDPE |
| References | 1. Krieg N. R. and Holt J. G., (Eds.), 1984, Bergeys Manual of Systematic Bacteriology Vol. I, P-408-51 |
| Customized Product Available | No |